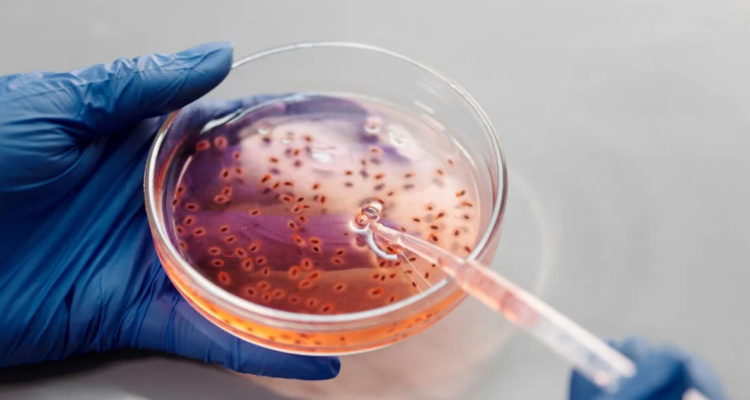
Revelan que cientos de frascos con virus mortales desaparecieron de un laboratorio en Australia

Una preocupante situación ha encendido las alarmas en el mundo científico -principalmente de la salud- esta semana, luego que se revelara que cientos de frascos con virus mortales desaparecieron de un laboratorio en Australia.
De acuerdo con Newsweek, el hecho fue confirmado por el ministro de Sanidad de Queensland, Tim Nicholls, precisando que unas 323 muestras de virus vivos se extraviaron del Public Health Virology Laboratory en 2021 -ubicado en dicho estado australiano-, catalogando lo ocurrido como un “grave incumplimiento de los protocolos de bioseguridad”.
Si bien el grave incidente ocurrió hace dos años, recién ahora las autoridades pudieron confirmar de manera oficial la desaparición de los peligrosos microorganismos. Esto, debido a la dilatada autorización para poder abrir los congeladores en donde se encontraban resguardadas las muestras, recoge Infobae.
Entre los ejemplares biológicos desaparecidos se encuentran cerca de 100 frascos con virus Hendra, 223 de Lyssavirus y al menos dos con Hantavirus.
La situación aún no ha sido esclarecida por las autoridades australianas y que se desconoce el paradero de las muestras extraviadas.
Desaparición de frascos con virus mortales en Australia: “Difícil que el público esté en riesgo”
Hasta ahora, han descartado que los frascos fueran robados con algún objetivo malicioso (como posibles armas biológicas), pero lo sucedido refleja la fragilidad de la seguridad encargada de resguardar estas muestras de peligrosos microorganismos que se encontraban en un laboratorio de alto nivel de bioseguridad.
Del mismo modo, se mantiene la interrogante sobre qué pudo ocurrir que permitiera esta ‘fuga’ de tales virus mortales, sin claridad a dos años del incidente.
Entre una de las hipótesis que se baraja, es que probablemente los frascos hayan sido destruidos de acuerdo con el protocolo habitual del laboratorio, según explicó el director de salud de Queensland, John Gerrard, consigna Newsweek.
“Es difícil concebir un escenario en el que el público pueda estar en riesgo. Es importante tener en cuenta que las muestras de virus se degradarían muy rápidamente fuera de un congelador de baja temperatura y dejarían de ser infecciosas”, resaltó. A su vez, aseguró que “no se han detectado casos de Hendra o Lyssavirus entre humanos en Queensland durante los últimos cinco años, y nunca ha habido informes de infecciones por Hantavirus en humanos en Australia”.







 Enviando corrección, espere un momento...
Enviando corrección, espere un momento...